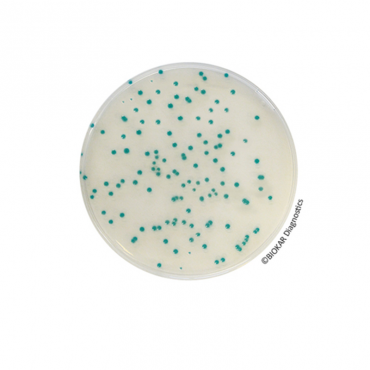

Rhapsody Agar® (PAE)
CAD$163,76

Supplément sélectif pour RHAPSODY Agar® :
10 flacons qsp 500 ml.
RHAPSODY Agar® est un milieu sélectif destiné au dénombrement de Pseudomonas spp. dans les produits alimentaires et les échantillons de l’environnement.
Téléchargement
Produits connexes